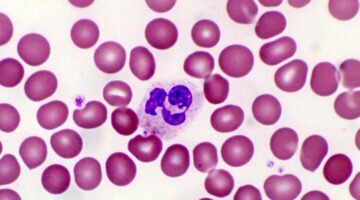
Нормы сегментоядерных нейтрофилов в крови человека

Важность типирования крови для человека
В организме человека кровь выполняет множество жизненно важных и необходимых функций. Именно она обеспечивает транспортировку необходимых для внутренних органов питательных микроэлементов, а также защищает организм в целом от многих необратимых процессов.
Нормы сегментоядерных нейтрофилов в крови человека
Все форменные элементы крови делятся на красные и белые кровяные тельца. Именно к белым кровяным тельцам или лейкоцитам относят сегментоядерные нейтрофилы.

О чем могут сигнализировать повышенные моноциты в крови?
Кровяные тельца в крови делятся на красные и белые по их цвету под микроскопом. Самым многочисленным отрядом среди белых кровяных телец являются лейкоциты. Они отвечают за противодействие организма различным внешним агентам, попадающим в него. К...

Поднимаем гемоглобин ребёнку самостоятельно: помочь, а не навредить
Наверняка в современном обществе не найдётся человека, не осознающего, какую роль для нормального функционирования организма играет гемоглобин. Одним из главных компонентов в формировании органических веществ, из которых на 34% состоит человеческое тело, помимо воды, микро-...

Гиповолемия. Симптомы и причины. Классификация
Уменьшение общего количества крови, находящейся в сосудах человека, называется гиповолемией. В нормальном здоровом состоянии у мужчин объём жидкой крови колеблется от 65 мл/кг до 75 мл/кг, а плазмы – 36–42 мл/кг. У здоровых женщин показатели...

Нормальны показатели содержания гемоглобина у женщин
Одним из главных показателей общего состояния организма человека является уровень гемоглобина, который в свою очередь собой представляет кровяные тельца, содержащие белковое вещество, а также такой важный элемент, как железо. Именно гемоглобин обеспечивает попадание кислорода ко...